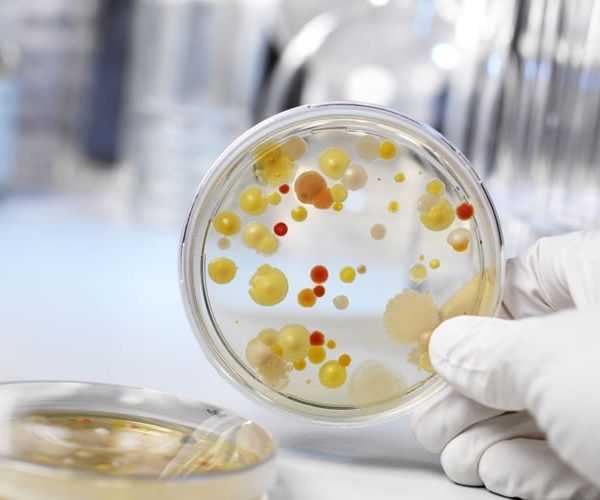
bakposev_1_17101745-e1489745891241.jpg
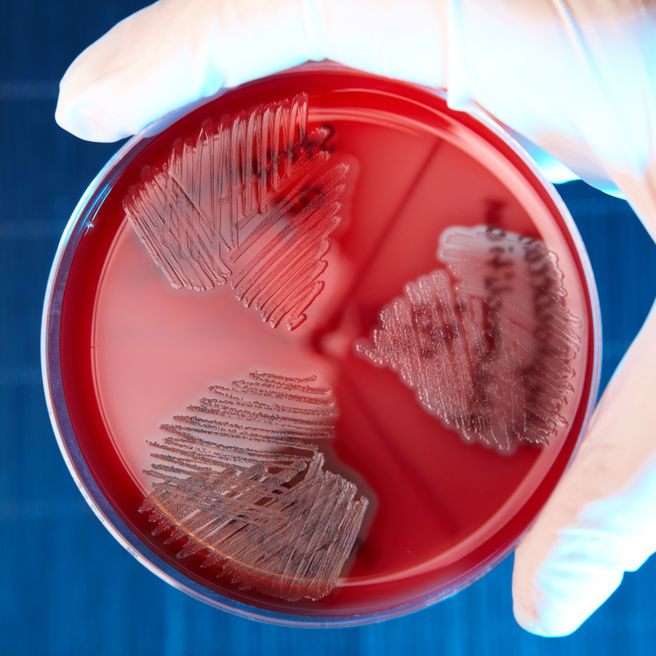
Бета-гемолитические стрептококки

Виды заболевания
Условия, в результате которых человек заболевает стрептококковыми болезнями, состоят из двух частей – ослабленный иммунитет и контакт с возбудителем инфекции. Часто паразит попадает в организм через дыхательные пути. В месте внедрения стрептококковой инфекции возникает воспалительный очаг гнойного характера.
- ОРВИ, ОРЗ;
- переохлаждение организма;
- грипп;
- туберкулез;
- тонзиллит;
- ВИЧ;
- травмирование слизистых оболочек носовой и ротовой полости;
- сахарный диабет;
- заболевания эндокринной системы.
Всех стрептококков делят на четыре группы (в зависимости от биохимических, биологических и прочих свойств):
- Альфа-гемолитические.
- Бета-гемолитические (А, В, С).
- Гамма-гемолитические.
- Негемолитические.
Негемолитические стрептококки для человека неопасны – никаких болезней они не вызывают, чего нельзя сказать об их гемолитических сородичах.
Так, альфа-гемолитические стрептококки являются причиной развития инфекционного эндокардита (воспаления внутренней оболочки сердца и поражения сердечных клапанов), гнойного периодонтита (воспаления соединительной ткани, окружающей корень зуба), а при проникновении во внутренние органы – абсцессов во внутренних органах. Кроме того, микроорганизмы данной группы играют ведущую роль в возникновении кариеса.
Бета-гемолитические стрептококки – наиболее патогенные среди всех стрептококков. Именно с ними связано развитие следующих заболеваний:
- Со стрептококками группы А – скарлатины, ангины, рожи, стрептодермии, гнойно-воспалительных процессов во внутренних органах, сепсиса, ревматизма, гломерулонефрита.
- Со стрептококками группы В (они особенно опасны для новорожденных) – кожных гнойничковых болезней, менингита и сепсиса у грудных детей. Эти микроорганизмы живут в мочеполовых органах 15-45% женщин и при наличии способствующих условий попадают в организм малыша внутриутробно или во время родов. При этом у мамы никаких проявлений стрептококковой инфекции может не быть, или же развиваются признаки воспаления мочевыводящих путей.
- Со стрептококками группы С – рожистого воспаления.
И наконец, гамма-гемолитические стрептококки в большинстве случаев являются сапрофитной (нормальной) микрофлорой кишечника и верхних дыхательных путей, которая все же при определенных условиях может вызвать инфекции мочевыделительной системы, ран, а также септический эндокардит.
В детском возрасте стрептококковая инфекция чаще всего протекает в форме скарлатины, а у взрослых – ангины. Если своевременно не начать прием антибиотиков при этих заболеваниях и допустить длительную персистенцию стрептококка в организме, возможно развитие ревматизма, эндокардита, артритов и гломерулонефрита.
Проявляется стрептококковая ангина следующими симптомами:
- Резким скачком температуры тела до высоких цифр (39 градусов и выше).
- Болью в горле.
- Слабостью, головной болью, ознобом.
- Ломотой в суставах.
- Увеличением небных миндалин (они как будто набухают и покрываются сначала мелкими гнойничками, а со временем – желтоватыми гнойными налетами).
- Увеличением шейных лимфоузлов.
Помимо поражения миндалин и внутренних органов (гнойные процессы в них не имеют характерных именно для стрептококковой инфекции симптомов), стрептококки вызывают специфические болезни кожных покровов:
- Рожу (рожистое воспаление). Это острое и часто рецидивирующее заболевание, при котором появляются общие симптомы (высокая температура, слабость, мышечная боль) и местные признаки инфицирования – красные пятна с четкими границами, возвышающиеся над кожей и покрывающие обширные участки тела, могут быть пузыри. Впервые рожистое воспаление появляется на лица, а рецидивирует чаще на нижних конечностях.
- Стрептодермию – стрептококковую пиодермию. Провоцирует развитие данного недуга загрязнение кожи, воздействие высоких или низких температур, варикозная болезнь, микротравмы и снижение иммунитета, вызванное стрессами и т.п. Поверхностная форма стрептодермии проявляется как импетиго. Развивается оно на открытых участках тела, в уголках рта, на крыльях носа, за ушными раковинами. Сначала появляются пятнисто-бугорковые высыпания, потом по порядку пузырьки, язвочки, медовые корочки, которые держатся несколько дней и исчезают бесследно. При более глубоком поражении кожи стрептококком развивается вульгарная эктима (формируются глубокие язвы), оставляющая после себя рубцы.
Стрептококк (Streptococcus) – род грамположительных факультативно-анаэробных бактерий из семейства Streptococcaceae. Существует больше 15 подтипов стрептококка, но самым распространенными являются альфа, бета и гамма. Альфа- и гамма-стрептококки являются частью нормальной микрофлоры ротовой полости, желудочно-кишечного тракта, дыхательной системы человека, не принося вреда организму. Опасными для здоровья человека являются бета-стрептококки.
Бактерии группы А чаще всего вызывают фарингит, ангину, импетиго, скарлатину, рожу, пневмонию, васкулит, гломерулонефрит, ревматизм, пародонтит, бронхит.
Стрептококк группы B поражает чаще мочеполовую систему, поскольку этот вид бактерии находиться у мужчин в уретре, у женщин – во влагалище.
Стрептококковая инфекция передается тремя путями:
- воздушно-капельным – распространение бактерий со слюной, слизью при кашле, чихании, крике;
- контактно-бытовым – при непосредственном контакте с больным или носителем инфекции, с бытовыми предметами, которыми пользовался больной;
- половым – через незащищенный половой акт.
Классификация Брауна (по степени вызываемого гемолиза):
Стрептококковая инфекция в урологии вызывает значительное беспокойство среди врачей. Специалисты отмечают, что стрептококки могут стать причиной различных заболеваний мочеполовой системы, включая цистит и уретрит. Эти бактерии, попадая в организм, могут вызывать воспалительные процессы, что приводит к неприятным симптомам, таким как боль при мочеиспускании и частые позывы. Врачи подчеркивают важность своевременной диагностики и лечения, так как игнорирование инфекции может привести к более серьезным осложнениям, включая пиелонефрит. Профилактика, включая соблюдение личной гигиены и укрепление иммунной системы, также играет ключевую роль в предотвращении стрептококковых инфекций. Важно, чтобы пациенты обращались к специалистам при первых признаках заболевания, чтобы избежать хронических форм инфекции.
Стрептококковая инфекция в урологии вызывает множество обсуждений среди пациентов и специалистов. Многие люди не осознают, что стрептококки могут стать причиной различных заболеваний мочеполовой системы. Симптомы, такие как боль при мочеиспускании, частые позывы и дискомфорт в области таза, часто воспринимаются как обычные признаки цистита или уретрита. Однако важно понимать, что стрептококки могут вызывать более серьезные осложнения, если не обратиться к врачу вовремя. Пациенты отмечают, что лечение включает антибиотики, но также важно соблюдать рекомендации по профилактике, чтобы избежать рецидивов. В целом, осведомленность о стрептококковой инфекции помогает людям быстрее реагировать на симптомы и получать необходимую медицинскую помощь.

Вопрос-ответ
Каковы симптомы стрептококковой инфекции мочеполовой системы?
У мужчин признаками поражения мочеполовой системы стрептококковой инфекцией могут быть зуд, жжение, болезненность во время мочеиспускания, слизисто-гнойные выделения из уретры. У женщин стрептококки могут вызывать такие инфекционные патологии, как вагинальный стафилококк, хламидиоз, трихомониаз.

Можно ли заразиться стрептококком при половом акте?
Стрептококки группы B являются частью нормальной микрофлоры влагалища и не являются заболеванием, передающимся половым путем.
Чем опасна стрептококковая инфекция?
Стрептококки – грамположительные аэробные организмы, вызывающие множество заболеваний, включая фарингит, пневмонию, инфекции ран и кожи, сепсис и эндокардит. Симптомы изменяются в зависимости от пораженного органа. Осложнения инфекции, вызванной БГСА, включают ревматическую лихорадку и гломерулонефрит.

Откуда берется стрептококк в мазке?
Пищевой — через зараженную еду — молочные, кисломолочные продукты, контактно-бытовой — через предметы, обсемененные бактериями, интранатальный — если половая система женщины поражена стрептококковой инфекцией.
Советы
СОВЕТ №1
Регулярно проходите медицинские осмотры и тесты на инфекции, особенно если у вас есть симптомы, такие как боль при мочеиспускании или выделения. Ранняя диагностика стрептококковой инфекции поможет избежать осложнений.
СОВЕТ №2
Обратите внимание на личную гигиену. Соблюдение правил чистоты, особенно в области половых органов, может снизить риск заражения стрептококками и другими инфекциями.
СОВЕТ №3
Если у вас уже диагностирована стрептококковая инфекция, строго следуйте предписаниям врача и завершайте курс антибиотиков, даже если симптомы исчезли. Это поможет предотвратить рецидив и развитие устойчивости к лекарствам.
СОВЕТ №4
Избегайте незащищенных половых контактов и старайтесь ограничить количество партнеров. Это поможет снизить риск передачи инфекций, включая стрептококковые.